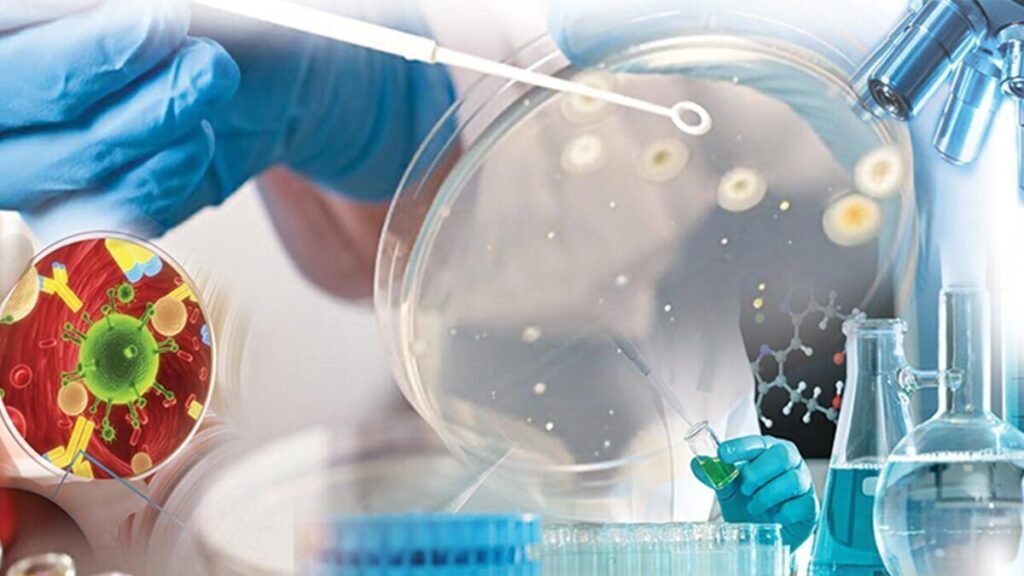

تعتزم مؤسسة العلوم الوطنية الإيرانية (INSF) تقديم دعم خاص للمفكرين والباحثين الرائدين في البلاد لدخول وتعميق الأبحاث في مجال البيولوجيا الكيميائية. لتوفير ثلاثة أضعاف الظروف الطبيعية من الخطط الأخرى للمفكرين والباحثين في هذا المجال.
الكيمياء الحيوية هي مجال مشترك بين الكيمياء والبيولوجيا. يتضمن هذا المجال استخدام التقنيات الكيميائية والتحليل، وغالبا ما يتم إنتاج الجزيئات الصغيرة من خلال الكيمياء التركيبية ، لدراسة النظم البيولوجية ومعالجتها. الكيمياء الحيوية هي مزيج من الكيمياء الحيوية العضوية وبيولوجيا الخلية وعلم العقاقير.
في هذا الفرع من العلم، يتم تقييم تفاعلات المواد الكيميائية التي تنطوي على جزيئات طبيعية صغيرة مثل الدهون والكربوهيدرات والببتيدات أو جزيئات الأدوية والمعادن. كما يتم يتم فحص تفاصيل آلية العمل.
تشمل الموضوعات الرئيسية المدعومة في هذه الدعوة أشياء مثل، تطوير بروتينات مستشعر الفلورسنت شبه الاصطناعية لقياس المستقلبات الرئيسية في الخلايا الحية ، وإنتاج جزيئات صغيرة للتحكم في وظيفة البروتين في الخلايا الحية ، وهندسة وظائف بروتينية جديدة للتطبيقات في البروتينات الوظيفية ، يتم توليف العلامات الطيفية الجديدة للتطبيقات في بيولوجيا الخلية بالإضافة إلى الدراسات الميكانيكية على الأدوية المرشحة.